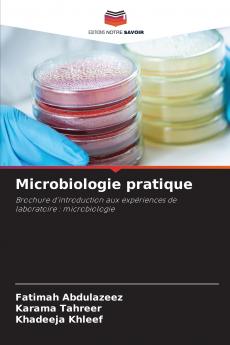
Microbiologie pratique

French
Paperback
₹5409
₹7127
24.11% OFF
(All inclusive*)
Delivery Options
Please enter pincode to check delivery time.
*COD & Shipping Charges may apply on certain items.
Review final details at checkout.
Looking to place a bulk order? SUBMIT DETAILS
Delivery Options
Please enter pincode to check delivery time.
*COD & Shipping Charges may apply on certain items.
Review final details at checkout.
About The Book
Description
Author(s)
Ce livre est un manuel de laboratoire axé sur les expériences de microbiologie plus particulièrement liées à l'identification et à la caractérisation des espèces de Mycobacterium y compris M. tuberculosis. Il comprend divers tests tels que le test au rouge neutre l'activité catalase la sensibilité à la pyrazinamide le test à l'amidase et le test de réduction des nitrates détaillant les propriétés biochimiques de ces bactéries. En outre il aborde les méthodes de filtration des bactéries l'utilisation de désinfectants tels que l'éthanol et l'isopropanol ainsi que les radiations pour la stérilisation. Dans l'ensemble cet ouvrage constitue un guide pratique pour les étudiants et les chercheurs en microbiologie.
Details
ISBN 13
9786208767532
Publication Date
-21-03-2025
Pages
-60
Weight
-95 grams
Dimensions
-152x229x3.65 mm